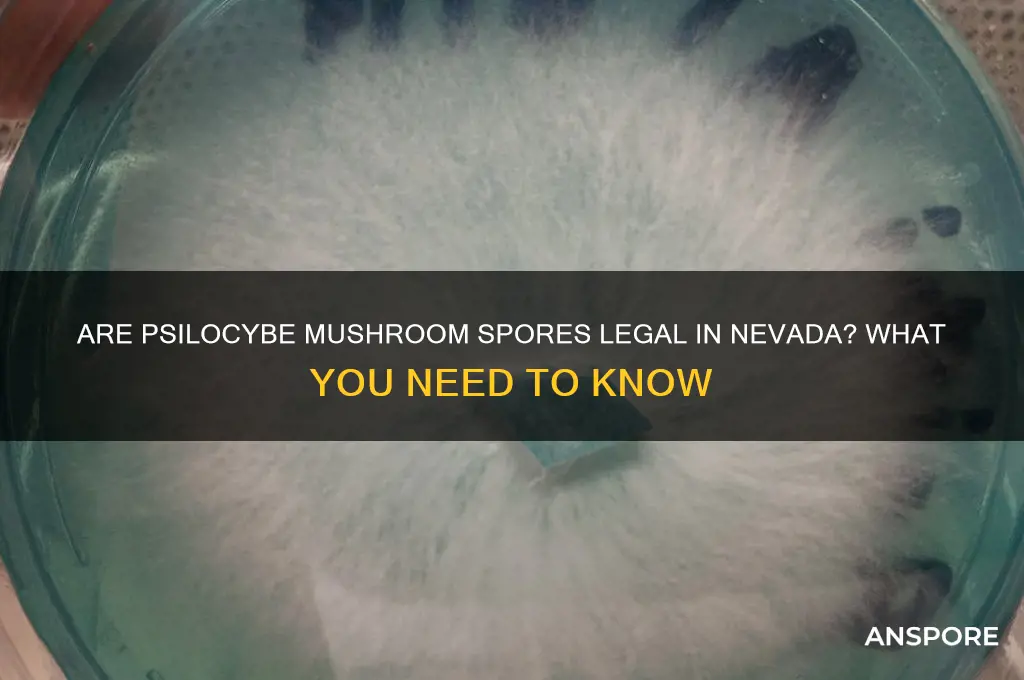
are psilocybe mushrooms spores legal in nevada

The legality of psilocybe mushroom spores in Nevada is a nuanced topic that reflects broader debates surrounding psychedelic substances. While psilocybin, the psychoactive compound found in these mushrooms, is classified as a Schedule I controlled substance under both federal and Nevada state law, the spores themselves exist in a legal gray area. Psilocybe mushroom spores do not contain psilocybin and are not explicitly outlawed in Nevada, making them technically legal to possess and purchase. However, cultivating these spores into mushrooms is illegal, as it results in the production of psilocybin. This distinction has led to a growing interest in spores for research, microscopy, or collection purposes, though individuals must navigate the legal complexities carefully to avoid unintended violations.
| Characteristics | Values |
|---|---|
| Legal Status of Psilocybe Mushroom Spores in Nevada | Psilocybe mushroom spores themselves are not explicitly illegal in Nevada. However, cultivating or possessing the mushrooms (fruiting bodies) is illegal under state law. |
| State Law Reference | Nevada Revised Statutes (NRS) 453.010 et seq. classifies psilocybin and psilocin (active compounds in psilocybe mushrooms) as Schedule I controlled substances. |
| Federal Law Reference | Under federal law (21 U.S.C. § 812), psilocybin and psilocin are Schedule I substances, but spores themselves are not regulated as long as they are not intended for cultivation. |
| Intent to Cultivate | Possessing spores with the intent to cultivate psilocybe mushrooms is illegal in Nevada and can lead to criminal charges. |
| Decriminalization Efforts | As of October 2023, Nevada has not decriminalized psilocybin mushrooms or their spores, unlike some other states (e.g., Oregon, Colorado). |
| Penalties for Possession | Possession of psilocybe mushrooms (not spores) can result in felony charges, fines, and imprisonment, depending on the quantity and circumstances. |
| Medical Use | Psilocybin is not approved for medical use in Nevada, though research and advocacy efforts are ongoing in other states. |
| Local Ordinances | Some Nevada counties or cities may have additional regulations, but state law governs controlled substances. |
| Commercial Sale of Spores | Selling spores for educational or research purposes is generally allowed, but marketing them for cultivation is illegal. |
| Enforcement | Law enforcement in Nevada focuses on cultivation and possession of mushrooms rather than spores alone. |
Explore related products
What You'll Learn

Current Nevada Psilocybe Spores Laws
In Nevada, the legal status of psilocybe mushroom spores hinges on their intended use. Possession of psilocybe spores themselves is not explicitly illegal under state law, as they do not contain the psychoactive compound psilocybin. However, cultivating these spores into mushrooms, which do contain psilocybin, is a felony offense. This distinction creates a legal gray area: while owning spores for microscopy or educational purposes may be permissible, using them to grow mushrooms for consumption is strictly prohibited.
This legal nuance reflects Nevada’s conservative stance on psychedelic substances. Unlike states like Oregon or Colorado, which have decriminalized or legalized psilocybin for therapeutic use, Nevada maintains stringent penalties for cultivation and possession of psilocybin-containing mushrooms. Individuals caught growing mushrooms from spores face severe consequences, including fines and imprisonment. Therefore, while spores may be technically legal to possess, their practical use is heavily restricted.
For those interested in studying psilocybe spores, Nevada’s laws require careful navigation. Vendors often sell spores with disclaimers emphasizing their legality for research or educational purposes only. Hobbyists must ensure their activities do not cross into cultivation, as this immediately triggers criminal liability. Practical tips include maintaining detailed records of spore purchases and their intended use, as well as avoiding any equipment or materials associated with mushroom cultivation, such as grow kits or substrates.
Comparatively, Nevada’s approach contrasts with jurisdictions that have embraced the therapeutic potential of psilocybin. For instance, Oregon’s Measure 109 allows regulated use of psilocybin in supervised settings, while federal research into its medical applications continues to expand. Nevada’s strict laws highlight the state’s reluctance to join this trend, leaving residents with limited options for exploring psilocybin’s benefits. This disparity underscores the importance of understanding local laws before engaging with psilocybe spores, even for seemingly innocuous purposes.
In conclusion, while psilocybe mushroom spores occupy a legal gray area in Nevada, their possession is only safe if strictly confined to non-cultivation uses. The state’s harsh penalties for growing psilocybin mushrooms serve as a strong deterrent, making it crucial for individuals to stay informed and compliant. As the national conversation around psychedelics evolves, Nevada’s laws may eventually shift, but for now, caution and clarity are paramount when dealing with psilocybe spores.
Endospore-Forming Organisms: Dangerous Pathogens or Harmless Survivors?
You may want to see also

Federal vs. State Regulations on Spores
The legality of psilocybe mushroom spores in Nevada hinges on a critical distinction: federal versus state regulations. Federally, psilocybin, the psychoactive compound in these mushrooms, is classified as a Schedule I controlled substance, making its possession, cultivation, and distribution illegal. However, spores themselves, which do not contain psilocybin, occupy a legal gray area under federal law. The Controlled Substances Act does not explicitly outlaw spores because they are not considered a drug. This federal loophole allows vendors to sell spores for "research or educational purposes" rather than for cultivation.
In Nevada, state law mirrors federal regulations regarding psilocybin but remains silent on spores. Nevada Revised Statutes (NRS) 453.011 et seq. classify psilocybin as a Schedule I substance, prohibiting its possession and use. Yet, like federal law, Nevada’s statutes do not address spores directly. This omission creates ambiguity, as spores are not explicitly banned but are often associated with the cultivation of illegal mushrooms. Law enforcement and prosecutors might interpret this gap differently, potentially leading to charges if spores are found alongside cultivation equipment or evidence of intent to grow psilocybin mushrooms.
For individuals navigating this legal landscape, understanding intent is crucial. While purchasing spores for microscopy or research is technically legal, cultivating psilocybin mushrooms from those spores is not. Nevada residents should be cautious, as even possessing spores could raise suspicion if authorities believe they are intended for illegal use. Practical tips include keeping spores in their original packaging, which often includes disclaimers about their legal use, and avoiding any paraphernalia associated with mushroom cultivation, such as grow kits or spore syringes.
The disparity between federal and state laws highlights a broader issue: the lack of clarity in regulating substances with both scientific and psychoactive potential. While federal law permits spores for non-cultivation purposes, Nevada’s silence on the matter leaves room for interpretation. This ambiguity underscores the importance of staying informed and exercising caution. For those interested in mycology or research, documenting the purpose of spore possession and avoiding any actions that could imply cultivation is essential to staying within legal boundaries.
In conclusion, while psilocybe mushroom spores are not explicitly illegal in Nevada, their legal status is precarious due to the overlap of federal and state regulations. Federal law permits spores for research, but Nevada’s focus on psilocybin prohibition creates a risk for individuals whose actions might be misinterpreted. Navigating this gray area requires careful consideration of intent, documentation, and adherence to legal disclaimers. As laws evolve, particularly with growing interest in psychedelic research, staying informed and cautious remains the best approach.
Understanding Mold Spores: Tiny Particles, Big Impact on Health and Homes
You may want to see also

Legal Uses of Psilocybe Spores
In Nevada, psilocybe mushroom spores are legal to possess, but their cultivation is strictly prohibited. This distinction creates a unique legal landscape where spores can be used for specific, non-cultivation purposes. One such legal use is mycological research, where scientists and hobbyists study the spores’ biological properties, life cycles, and genetic makeup. These studies contribute to advancements in botany, ecology, and even medicine, as understanding fungal biology can lead to breakthroughs in areas like soil health and disease resistance. For those interested in this field, acquiring spores from reputable vendors and maintaining detailed records of experiments ensures compliance with state laws.
Another legal application of psilocybe spores is art and microscopy. Enthusiasts often use spores to create intricate spore prints or slides for microscopic examination, turning scientific observation into a creative endeavor. To engage in this practice, start by sterilizing your workspace and equipment to prevent contamination. Place a mature mushroom cap gill-side down on a piece of paper or glass slide for 24 hours to capture the spore drop. These prints can be framed as unique artwork or studied under a microscope to appreciate the spores’ intricate structures. Always label your work clearly to avoid confusion with illegal substances.
Educational purposes also provide a legal avenue for using psilocybe spores. Teaching institutions and workshops may use spores to demonstrate fungal biology, taxonomy, or forensic science. For example, instructors can show students how to identify different spore species under a microscope or explain their role in ecosystems. If you’re an educator, ensure your activities align with Nevada’s legal framework by avoiding any mention or implication of cultivation. Providing context about the legal and ecological significance of spores can enrich the learning experience while fostering respect for the law.
Finally, preservation and conservation efforts represent a lesser-known but vital legal use of psilocybe spores. As natural habitats face threats from climate change and development, collecting and storing spores in spore banks helps safeguard fungal biodiversity for future generations. Organizations or individuals involved in this work must adhere to ethical guidelines, such as obtaining spores from sustainable sources and avoiding over-harvesting. By participating in or supporting these initiatives, you contribute to the long-term survival of psilocybe species while staying within Nevada’s legal boundaries.
Understanding Spore Plants: A Beginner's Guide to Their Unique Life Cycle
You may want to see also
Explore related products

Penalties for Illegal Spores Possession
In Nevada, the legality of psilocybe mushroom spores hinges on their intended use, but possession with the intent to cultivate or distribute psychoactive mushrooms can lead to severe penalties. While spores themselves do not contain psilocybin, the state’s Controlled Substances Act treats them as illegal if linked to cultivation. Penalties vary based on quantity and intent, with possession for personal use typically classified as a misdemeanor, punishable by up to 6 months in jail and a $1,000 fine. However, larger quantities or evidence of distribution can escalate charges to a felony, carrying up to 5 years in prison and fines up to $10,000. Understanding these distinctions is critical for anyone navigating Nevada’s legal landscape regarding psilocybe spores.
For those caught with spores, the legal process often begins with a search and seizure, where law enforcement looks for evidence of cultivation, such as grow kits, mycology guides, or digital records. Even small amounts of spores can trigger charges if paired with paraphernalia suggesting intent to cultivate. First-time offenders may qualify for diversion programs, which allow for charges to be dropped upon completion of drug education or community service. However, repeat offenses or large-scale operations face harsher consequences, including asset forfeiture and extended probation. Consulting a legal expert is advisable to navigate these complexities and build a robust defense.
Comparatively, Nevada’s penalties align with neighboring states like California and Arizona, where spores are legal to possess but illegal to cultivate. However, Nevada’s enforcement is notably stricter, with prosecutors often pursuing maximum penalties for felony cases. This contrasts with Oregon, where psilocybin has been decriminalized for therapeutic use, highlighting the divergent approaches to psychedelic substances across the U.S. For individuals in Nevada, the takeaway is clear: while spores may seem innocuous, their possession carries significant legal risk if tied to cultivation.
Practical tips for avoiding penalties include refraining from purchasing spores from unverified sources, as some vendors may inadvertently implicate buyers in illegal activities. Additionally, maintaining clear boundaries between mycological study and cultivation is essential. For instance, labeling spores as “for microscopy use only” and storing them separately from any growing equipment can help establish lawful intent. Finally, staying informed about legislative changes is crucial, as the legal status of psychedelics is evolving rapidly, with potential reforms on the horizon.
Mold Spores Everywhere: Unseen, Ubiquitous, and Potentially Harmful?
You may want to see also

Trends in Nevada Psilocybe Legislation
In Nevada, the legal status of psilocybe mushroom spores reflects a broader national trend toward reevaluating psychedelic substances. Unlike the fruiting bodies of psilocybe mushrooms, which contain the psychoactive compound psilocybin and are classified as Schedule I controlled substances under federal law, spores themselves do not contain psilocybin. This distinction has created a legal gray area, allowing spores to be sold and possessed in many states, including Nevada, for non-cultivation purposes such as microscopy or collection. However, Nevada’s stance is nuanced, with no explicit state laws banning spores, but cultivation remains illegal, punishable by severe penalties.
Analyzing recent legislative trends, Nevada has shown cautious openness to psychedelic reform. In 2023, Senate Bill 242 was introduced to decriminalize possession of small amounts of psychedelics, including psilocybin mushrooms, for personal use. While the bill did not pass, it signaled a shift in public and legislative attitudes. This mirrors national trends, such as Oregon’s Measure 109, which legalized psilocybin for therapeutic use, and Colorado’s Proposition 122, decriminalizing personal use of psychedelics. Nevada’s consideration of such measures suggests growing recognition of psychedelics’ therapeutic potential, particularly for mental health conditions like depression and PTSD.
For those navigating Nevada’s current laws, practical caution is essential. While spores are not explicitly illegal, cultivating psilocybe mushrooms from spores is a felony, carrying potential prison time and fines. Vendors often label spores as “for microscopy use only” to comply with legal loopholes, but intent matters in court. Individuals should avoid discussing cultivation plans or sharing spores with others, as this could escalate legal risks. Additionally, staying informed about pending legislation is crucial, as Nevada’s psychedelic policies may evolve rapidly in response to national trends and scientific research.
Comparatively, Nevada’s approach differs from states like California and Idaho, where spores are explicitly illegal. This variation highlights the patchwork nature of psychedelic legislation across the U.S. and underscores the importance of state-specific research. For instance, while Nevada permits spore possession, neighboring Utah maintains strict prohibitions. Such disparities emphasize the need for clarity and advocacy in harmonizing laws with scientific evidence and public health priorities.
In conclusion, Nevada’s psilocybe spore legislation is emblematic of a cautious yet progressive shift in psychedelic policy. While spores remain legal for non-cultivation purposes, the state’s flirtation with decriminalization bills indicates a growing acceptance of psychedelics’ therapeutic value. For residents and enthusiasts, understanding these nuances is critical to avoiding legal pitfalls. As national momentum builds for psychedelic reform, Nevada’s trajectory will likely continue to reflect broader trends, making it a state to watch in the evolving landscape of psychedelic legality.
Are All Anaerobes Spore-Forming? Unraveling the Microbial Mystery
You may want to see also
Frequently asked questions
Yes, psilocybe mushroom spores are legal to possess in Nevada because they do not contain psilocybin or psilocin, the controlled substances found in grown mushrooms.
No, cultivating psilocybe mushrooms is illegal in Nevada, as the grown mushrooms contain psilocybin, a Schedule I controlled substance under state and federal law.
No, psilocybe mushroom spores are not classified as drug paraphernalia in Nevada, as they are not intended for use in growing illegal substances, though cultivation is prohibited.
Yes, buying and selling psilocybe mushroom spores is legal in Nevada, as they are not regulated under state law, but they cannot be used for illegal cultivation.
Growing psilocybe mushrooms in Nevada is a felony offense, punishable by significant fines and potential imprisonment, as it involves producing a controlled substance.































